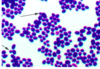

Introduction to Microbial World (Bacteria) Flashcards
(35 cards)
what are the relationships between humans and microbiota?
symbiosis = the long-term interaction between 2 different biological species

what is an infection?
what is the difference between a primary pathogen and an opportunistic pathogen?
infection: multiplication of a bacterial pathogen within the host
- *primary pathogen:** causes disease when infection - not normally associated with host
- *opportunistic pathogen:** only causes disease in compromised host: sometimes part of normal flora
virulence: quantative ability of a microbe to cause disease
what are 4 basic microbes that can cause pathogens?
what kingdom are they each/
- *1. bacteria:** prokaryote
- *2. viruses:** non living
- *3. fungi:** eukaryote
- *4. protoza:** eukaryote
how do bacteria store DNA?
other general strucutture like?
- orgenelles like what?
- around outside?
how divide?
- *DNA/RNA:**
- *- single circular chromosome** that lies free in cytoplasm
- *-** sometimes: additional plasmids
structure:
- *-** free floating / non membrane organelles
- cell wall
- can have: flagella (motility)
- pili / fimbriae: adherence
- 70S rb (50S & 30S)
Division:
binary fission
what is S of bacteria ribosomes?
70S ribosomes (two subunits with densities of 50S and 30S)
what are some bacteria covered in?
what are pili used for?
what are bacteria spores?
some bacteria: capsulate (polysaccaride). evades immune response
pili: adherence to surfaces
bacterial spores: structures very resistant to physical & chemical agents. often go into dormant state. e.g. Bacillus anthracis, C. difficile
name functions of bacterial cell wall
what are the two different types of bacterial cell wall?
function:
- protects agaisnt desiccation, osmotic shock & mech. shock
- protection agaisnt host immune system: specifc and non-specific
- adherence to surfaces
types:
- *- gram postive
- gram negative**
what determines if bacterial cell wall is gram postive or gram negative?
what else is different between them?
what colours do they stain?
depends on level of peptidoglycan: (and therfore the staining)
- *- thick peptidoglycan:** gram postive - purple stain
a) just one membrane
b) lipotechoic acids sticking out - *- thinner peptidoglycan:** gram negative - negative stain
a) have inner and outer membranes
b) lipopolysaccarides sticking out
c) holes in outermembrane

which one of these is gram +ve / -ve?

+ve = left / -ve right
what are 3 main shapes of bacteria?
Spherical (cocci)
Cylindrical rod (bacilli)
Curved/spiral (spirochetes)

differences between bacteria and eu cells?
- nucleus: eukaryotes - membrane-bounded, bacteria: floating (also plasmids)
- RB: eukaryotes: 80S (60S & 40S), bacteria: 70S (50S & 30S)
- organelles: eukaryotes - mitochondria, golgi apparatus, lysosomes, peroxisomes and ER, bacteria: not those
bacteria divide by binary fission
what does gram stain rely on to show differences in bacteria?
what stain do u use for: a) Mycobacteria, b) fungi & c) spirochaetes? (probs dont need to know tbh)
differences in cell wall (amount of peptidoglycan):
- *- gram postive** = purple
- *- gram negative =** pink
- ( a) Mycobacteria: Zielh-Nielson stain
b) fungi: Cotton blue stain
c) spirochaetes: darkfield microscopy )*
process of gram staining?
Gram stain: Crystal violet –> Iodine –> Ethanol –> Safranin
how are gram postive cocci subclassed? how do u test?
gram postive cocci - to differentiate between cocci do catalase test
- streptococci: catalase negative
- straphylocci: straphylocci positiive
subclassify straphylocci further: coagulase stain:
- **straphylocci coagulase +ve
- straphylocci coagulase -ve**
subclassify Streptococci further:: if can lyse blood or not
- *- beta-haemolytic: lyse blood - complete haemolysis
- alpha-haemolytic:: partially lyse blood
- non-haemolytic: dont**
how do subdivde & test for different:
a) Staphylococci?
b) streptoccoi?
- *staphylococci**: if can coagulate human serum or not
- S. aureus (important human pathogen):* coagulates human serum: coagulase positive
- S. epidermidis (non disease):* does not coagulate human serum: coagulase negative
- *Streptococci:** if can lyse blood or not
- beta-haemolytic: lyse blood - complete haemolysis
- alpha-haemolytic:: partially lyse blood
- non-haemolytic: dont
what are staphylococcal disesases - localised and systemic/>
- *localised:
- pyogenic (**pus making)
- abscesses
- wound infections
- follicultis
- *- MSK:**
- osteomyelitis
- *- Resp infection:**
- sinustis
- pneumonia
- *generalised, systemic** (into blood)
- bacteraemia, sepsis, endocarditis (infection of heart)
name 3 staphylococcoal diseases that caused by entrotoxins?
- acute staph. enterocolitis (food pois)
- *2. staphylococcal ‘scalded skin’ syndrome:**
- Ritters disease
- caused by exofoliative exotoxin
- *3. toxic shock sydrome**
- severe immune response to certain strains of staph. cause superantigens: high fever, rash, low BP, coma, multple organ failure
difference in structure of steptococci and staphylococci bacteria?
streptococcus: chains
staphylococcus: clusters

how are beta-haemolytic steptococci divided?
groups: A-G
depends on which Lancefield antigen is detected on surface
disease caused by Streptococcus pyogenes (Group A)?
- Streptococcus pyogenes* (Group A)
- sore throat
- fever
- rash (strawberry tongue) - scarlet fever
- tonislitis
- infection of upper dermis. if on face: erysipelas ; arm: cellulitis. deeper that skin: can develop into sepsis, flesh eating strep
gram negative rod bacteria?
2 main groups?
gram negative rods:
-
Obligate pathogens:**
1. Salmonella sp: S. typhi, S. paratyphi*
2. Shigella sp: S. dysenteriae, S flexneri, S. sonnei, S. boydii
3. Klebsiella pneumoniae
4. Yersinia sp: Y. entrocolticia, pseudotuberculosis - *Opportunistic pathogens** (mostly live in our gut):
1. Escherichia coli
2. Enterobacter sp: E. aerogenes, cloacae
3. Acinetobacter baumanii
what are enterobacteriaciae?
Enterobacteriaceae are a large family of Gram-negative bacteria that includes a number of pathogens such as Klebsiella, Enterobacter, Citrobacter, Salmonella, Escherichia coli, Shigella, Proteus, Serratia and other species.
These pathogens are present in the human intestinal tract and are a normal part of the gut flora.
what happens when enterobacteriaciae leave gut?
not good !
quite serious:
- wound infection
- UTI
- septicaemia
- neurosurgial meningitis
- pneumonia
how can u classify enterobacteriaciae?
- *- fermentors
- non-fermentors**
- *fermentors**:
- bacteria differ in their ability to produce acids from different sugars (monosac, disac, polysac and alchohol fermentation). used to differentiate bacteria.